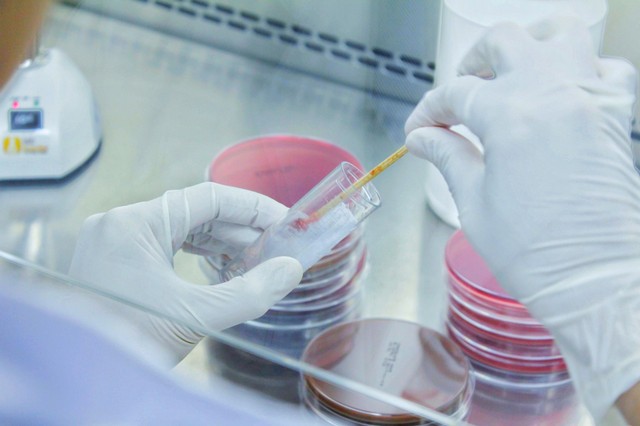
Mire utal a kóros köpetürítés?

Véres köpet

A tüdőrák alattomos jelei: így üzen a test, mielőtt túl késő lenne
A tüdőrák kezdeti tünetei általában általánosak, ami megnehezíti a korai diagnózist.

Rosszindulatú daganat előjelei: ne hagyja figyelmen kívül ezt a 7 tünetet!
Kutatók összegyűjtötték azokat a jeleket, amelyek leggyakrabban utalhatnak a szervezetben rákra.

Az orvos szerint ez az egyszerű hüvelykujj teszt halálos szívbetegséget is jelezhet
Súlyos problémára hívhatja fel a figyelmet az, ha ezt meg tudja csinálni a hüvelykujjával.

Tartós, nem múló rekedtség: ciszta, daganat, de akár polip is kiválthatja
Mi az oka annak, ha tartósan rekedtek vagyunk?

Tüdőrák: ez a 4 korai tünet már a betegség kezdetén jelzi a tumort
A tüdőrák az egyik leggyakoribb rákos betegség. Ezekre figyeljen!

A tüdőrák diagnosztizálásához önmagában kevés a hagyományos tüdőszűrés - tudja meg, miért
Mikor elég a tüdőröntgen, és mikor van szükség CT-re?

Mire utal a véres köpet?
Ezek lehetnek a véres köpet okai, társtünetei, kivizsgálási és kezelési lehetőségei.
Mire utal a kóros köpetürítés?
A légutakat érintő betegségek, fertőzések megváltoztatják a nyálkahártya által normál esetben is termelt váladékot. Ez a kóros váladék hurutos, produktív köhögés vagy köpetürítés során távozik a szervezetből. A kóros köpetürítés vizsgálata segíthet a légúti panaszok okának felderítésében. Tudjon meg mindent az okáról, kialakulásáról, kezeléséről.